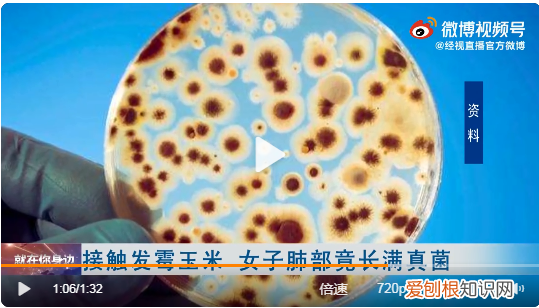
女子接触霉变玉米后肺部长满真菌

每经编辑:杜宇

文章插图
12月8日早间,“女子接触霉变玉米后肺部长满真菌”冲上热搜第一 。
据人民网,一23岁女子前段时间回老家帮忙收玉米,事后连续1个多月咳喘不止 。经医生检查,她的肺部长满了黄曲霉菌,引发了真菌感染 。据该女子回忆,当时她主要负责将晾晒的玉米收进袋子中,有些玉米可能淋雨霉坏,而她没有做任何防护措施 。

文章插图
武汉市第四医院呼吸与危重症医学科住院医生郭蒲剑表示:“她肺上的感染和一般的肺炎不是很相似,她是慢性的咳嗽、低烧 , 肺部病变的范围比较广、比较大 。”
文章插图
郭蒲剑称,因为黄曲霉菌是比较广泛的存在于腐败或是一些受潮的谷物,她当时没有戴口罩也没有做好防护,吸入了一些霉菌真菌,真菌可能在她的肺上产生了定植 。有呼吸道基础疾病的病人,外出最好做一些保护性措施,注意周围环境卫生 。
什么是黄曲霉毒素?
我国于1972、1973、1974及1981年先后在全国进行食品中AFB1的普查工作 , 结果发现黄曲霉毒素的污染有地区和食品种类的差别 。长江及长江以南地区黄曲霉毒素污染严重,北方各省污染较轻 。在各类食品中 , 花生、花生油、玉米污染最严重,大米、小麦、面粉污染较轻,豆类很少受到污染 。
黄曲霉毒素是一种剧毒的致肝癌物质,其中黄曲霉毒素B1可引起细胞错误地修复DNA,导致严重的DNA诱变,还可抑制DNA和RNA的合成 , 从而抑制蛋白质的合成 。
人摄入大剂量的黄曲霉毒素后可出现肝实质细胞坏死、胆管上皮细胞增生、肝脂肪浸润及肝出血等急性病变 , 前期症状为发烧、呕吐、厌食、黄疸,继而出现腹水 , 下肢浮肿并很快死亡 。

文章插图
每日经济新闻综合人民网、公开资料
【女子接触霉变玉米后肺部长满真菌】每日经济新闻
推荐阅读
- 南通市容公司将老人2000根甘蔗全买下
- 梅姨案被拐儿童找回后将生母拉黑,网友痛批人贩子
- 官方回应桂林多名密接者信息遭泄露
- 苏泊尔炒锅哪种好质量怎么样
- 索尼a7c和rx 100对比评测哪个更值得买
- s500rf支持杜比全景声吗
- 按摩仪器哪一个牌子好用
- 帽子比较好的品牌有哪些
- 松下F-60C1YXC除湿机怎么样
